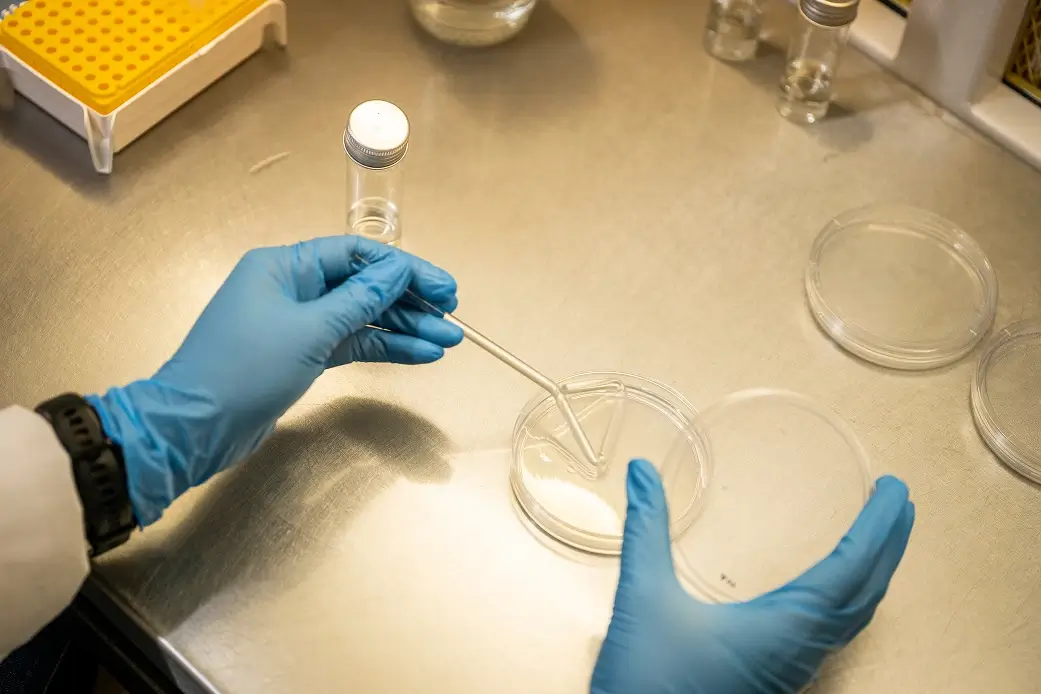
Sterile Laboratories

Science That Sustains. Solutions That Perform.
Through cutting-edge fermentation and formulation science, Andermatt PHP creates biological products that meet global standards
Our Vision
Healthy Food and Healthy Environment, For All
We envision a world where people and planet thrive together.
Driven by a culture of care, integrity, and curiosity, APHP will set the global standard for reliable and innovative biological crop solutions. Together, we are driving the future of sustainable food systems and creating enduring impact for generations to come.
Our Products
Bio-Insecticides
Bioinsecticides are biologically-derived products used to control insect pests in a safe and environmentally friendly way.
Bio-Fungicides
Biofungicides protect plants from fungal diseases by using beneficial microbes or natural compounds to suppress pathogens and strengthen plant immunity.
Research & Innovation
We leverage advanced solid-state fermentation technology and formulation science to create products that are both effective and environmentally responsible. Our commitment to evidence-based innovation drives us to continuously explore new ways to enhance crop health and productivity.
Authentically aphp
At APHP, culture comes to life through authenticity and action. Authentically APHP is our promise to stay true to who we are, live our values boldly, and lead with integrity.

Our mission
By working with nature, we deliver outstanding and innovative biological solutions to global agriculture through evidence-based science, teamwork, trust, and unwavering integrity.
Why aphp?

-
Biological Pioneers
Founded by renowned scientists, APHP has over 27 years of experience in pioneering biological crop solutions rooted inrigorous research and innovation.
-
Global Reach, South African Innovation
As part of the international Andermatt Group, APHP combines South African ingenuity with global partnerships to deliver world-class biological products.
-
Built on Innovation, Driven by Purpose
APHP leads in solid-state fermentation and formulation science, producing environmentally responsible solutions that are both effective and sustainable.
-
Quality, Compliance, and Efficacy You Can trust
At Andermatt PHP, quality is a commitment. Every product wedeliver is the result of meticulous science, rigorous testing, andunwavering standards.
-
A People-Centred Culture
At Andermatt PHP, our people are the heart of everything we do.Their passion, expertise, and dedication fuel our innovation and shape our impact.


